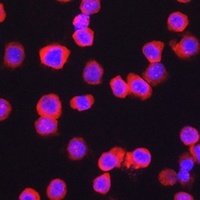
CD11b Rabbit Polyclonal Antibody

You have no items in your shopping cart.
CD11b Rabbit Polyclonal Antibody
Description
Research Area
Images & Validation
−| Tested Applications | WB |
|---|---|
| Dilution Range | WB=1:500-2000 |
| Reactivity | Human, Mouse, Rat |
| Predicted Reactivity | Porcine |
Key Properties
−| Antibody Type | Primary Antibody |
|---|---|
| Host | Rabbit |
| Clonality | Polyclonal |
| Isotype | IgG |
| Immunogen | KLH conjugated synthetic peptide derived from mouse CD11b (77-180/1152aa) |
| Target | ITGAM |
| Molecular Weight | 165-170 kDa |
| Purification | Affinity purified by Protein A |
| Conjugation | Unconjugated |
Storage & Handling
−| Storage | Maintain refrigerated at 2-8°C for up to 2 weeks. For long term storage store at -20°C in small aliquots to prevent freeze-thaw cycles. |
|---|---|
| Form/Appearance | Liquid |
| Buffer/Preservatives | 0.01M TBS (pH7.4) with 1% rAlbumin, 0.02% Proclin300 and 50% Glycerol. |
| Concentration | 1mg/ml |
| Expiration Date | 12 months from date of receipt. |
| Disclaimer | For research use only |
Alternative Names
−Similar Products
−CD11b/ITGAM Rabbit Polyclonal Antibody [orb215894]
FC, IHC, WB
Human, Mouse, Rat
Rabbit
Polyclonal
Unconjugated
100 μgCD11b Rabbit Polyclonal Antibody [orb1294243]
IHC, WB
Human
Rabbit
Polyclonal
Unconjugated
100 μl, 25 μlCD11b Rabbit Polyclonal Antibody [orb1474648]
IF, IHC, WB
Human, Mouse, Rat
Rabbit
Polyclonal
Unconjugated
100 μl, 50 μl, 200 μl, 30 μlCD11b Rabbit Polyclonal Antibody [orb1294264]
IHC, WB
Mouse, Rat
Rabbit
Polyclonal
Unconjugated
100 μl, 25 μlCD11b/ITGAM Rabbit Polyclonal Antibody [orb413002]
ELISA, FC, IHC, WB
Human, Mouse
Rabbit
Polyclonal
Unconjugated
100 μg

Quality Guarantee
Explore bioreagents carefree to elevate your research. All our products are rigorously tested for performance. If a product does not perform as described on its datasheet, our scientific support team will provide expert troubleshooting, a prompt replacement, or a refund. For full details, please see our Terms & Conditions and Buying Guide. Contact us at [email protected].

Blank control: U937 (blue). Primary Antibody: Rabbit Anti-CD11b antibody (orb11009), Dilution: 1 µg in 100 µl 1X PBS containing 0.5% BSA, Isotype Control Antibody: Rabbit IgG (orange), used under the same conditions, Secondary Antibody: Goat anti-rabbit IgG-PE (white blue), Dilution: 1:200 in 1 X PBS containing 0.5% BSA. Protocol, The cells were fixed with 2% paraformaldehyde (10 min). Primary antibody (orb11009, 1 µg/1x10^6 cells) were incubated for 30 min on the ice, followed by 1 X PBS containing 0.5% BSA + 1 0% goat serum (15 min) to block non-specific protein-protein interactions. Then the Goat Anti-rabbit IgG/PE antibody was added into the blocking buffer mentioned above to react with the primary antibody at 1/200 dilution for 30 min on ice. Acquisition of 20000 events was performed.

Sample: Lane 1: Mouse Lymph node tissue lysates, Lane 2: Mouse Spleen tissue lysates, Lane 3: Rat Spleen tissue lysates, Primary: Anti-CD11b (orb11009) at 1/1000 dilution, Secondary: IRDye800CW Goat Anti-Rabbit IgG at 1/20000 dilution, Predicted band size: 125 kDa, Observed band size: 175 kDa.
Quick Database Links
UniProt Details
−Documents Download
Request a Document
Filter by Applications
Filter by Species
Liu, Qiang et al. Valproic acid attenuates inflammation of optic nerve and apoptosis of retinal ganglion cells in a rat model of optic neuritis Biomed Pharmacother, 96, 1363-1370 (2017)
Applications
Reactivity
Elsherbiny, Nehal M. et al. Inhibitory effect of valproate sodium on pain behavior in diabetic mice involves suppression of spinal histone deacetylase 1 and inflammatory mediators Int. Immunopharmacol., 70, 16-27 (2019)
Applications
Reactivity
Bai, Lijuan et al. Somatostatin prevents lipopolysaccharide-induced neurodegeneration in the rat substantia nigra by inhibiting the activation of microglia Mol Med Rep, 12, 1002-1008 (2015)
Applications
Reactivity
Jung Hwan Park 1, Ki-Chun Yoo 2, Seung Bum Lee 2, Mineon Park 3, Han Byul Kim 1, Minji Kang 1, Sang-Pil Choi 1, Jeong-Won Kim 1, Sunhoo Park 3, Won Il Jang 3, Hae-June Lee 4, Sehwan Shim 5, Hyosun Jang AZD 9668, a neutrophil elastase inhibitor, promotes wound healing in the irradiated skin by inhibiting NET-derived vascular dysfunction Int Immunopharmacol ., (2025)
Applications
Reactivity
CD11b Rabbit Polyclonal Antibody (orb11009)
Participating in our Biorbyt product reviews program enables you to support fellow scientists by sharing your firsthand experience with our products.
Login to Submit a Review